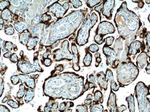
Placental lactogen Antibody in Immunohistochemistry (Paraffin) (IHC (P))

Search
Proteintech
Placental lactogen Polyclonal Antibody
{{$productOrderCtrl.translations['antibody.pdp.commerceCard.promotion.promotions']}}
{{$productOrderCtrl.translations['antibody.pdp.commerceCard.promotion.viewpromo']}}
{{$productOrderCtrl.translations['antibody.pdp.commerceCard.promotion.promocode']}}: {{promo.promoCode}} {{promo.promoTitle}} {{promo.promoDescription}}. {{$productOrderCtrl.translations['antibody.pdp.commerceCard.promotion.learnmore']}}
产品信息
16326-1-AP
种属反应
宿主/亚型
分类
类型
抗原
偶联物
形式
浓度
纯化类型
保存液
内含物
保存条件
运输条件
产品详细信息
Immunogen sequence: MAAGSRTSL LLAFALLCLP WLQEAGAVQT VPLSRLFDHA MLQAHRAHQL AIDTYQEFEE TYIPKDQKYS FLHDSQTSFC FSDSIPTPSN MEETQQKSNL ELLRISLLLI ESWLEPVRFL RSMFANNLVY DTSDSDDYHL LKDLEEGIQT LMGRLEDGSR RTGQILKQTY SKFDTNSHNH DALLKNYGLL YCFRKDMDKV ETFLRMVQCR SVEGSCGF (1-217 aa encoded by BC022044)
靶标信息
The human growth hormone (GH) locus is comprised by two GH (GH1 and GH2) genes and three chorionic somatomammotropin (CSH1, CSH2 and CSH-L) genes. Placental lactogens (CSH1, CSH2) are produced in the mammalian placenta and are similar in structure and function to growth hormones. Together, placental lactogens and growth factors play an essential role to assure successful lactation after pregnancy. Placental lactogens also modify the metabolic state of the mother during pregnancy to supply energy to the fetus. Both CSH1 and CSH2 can be detected by this antibody.
仅用于科研。不用于诊断过程。未经明确授权不得转售。
篇参考文献 (0)
生物信息学
蛋白别名: Choriomammotropin; chorionic somatomammotropin A; chorionic somatomammotropin B; Chorionic somatomammotropin hormone 1; chorionic somatomammotropin hormone 1 (placental lactogen); Chorionic somatomammotropin hormone 2; chorionic somatomammotropin-1; growth hormone B1; growth hormone B3; Lactogen; PL; Placental lactogen
基因别名: CS-1; CS-2; CSA; CSB; CSH1; CSH2; CSMT; GHB1; GHB3; hCS-1; hCS-A; hCS-B; PL
UniProt ID: (Human) P0DML2, (Human) P0DML3
Entrez Gene ID: (Human) 1442, (Human) 1443